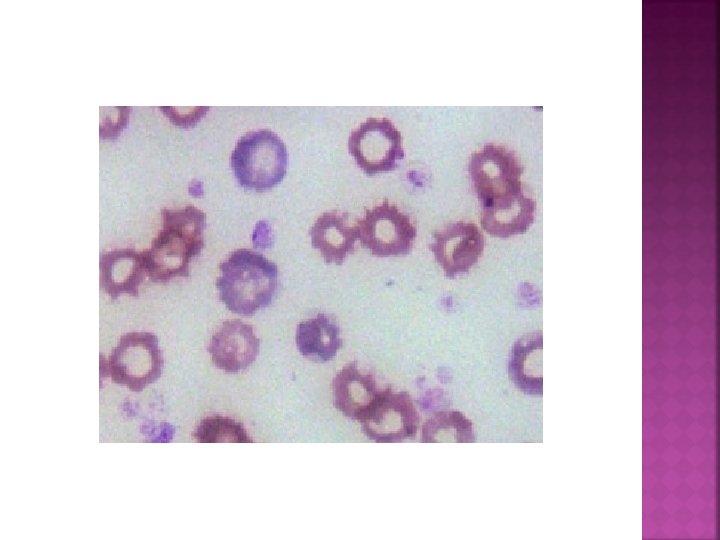
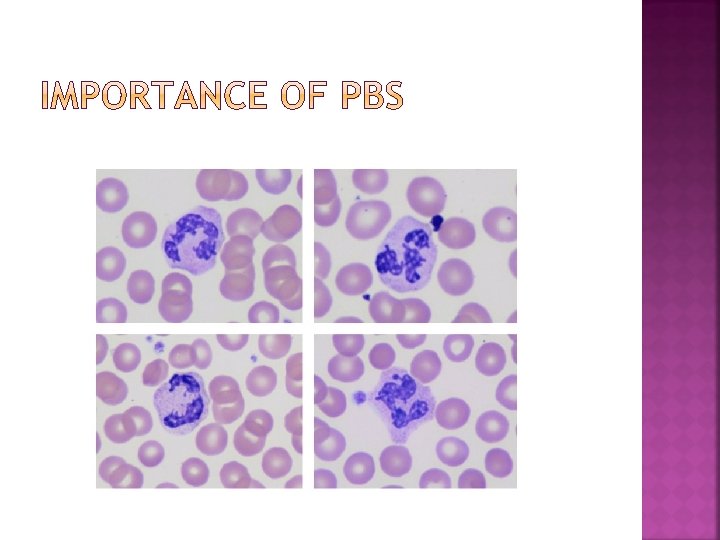
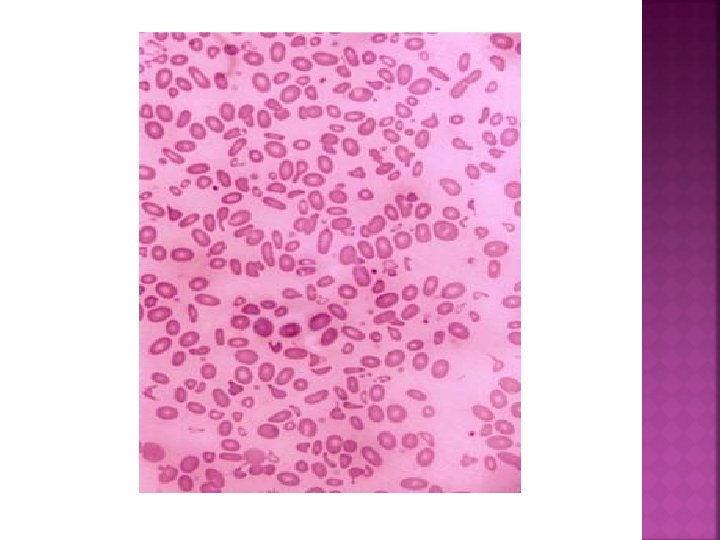
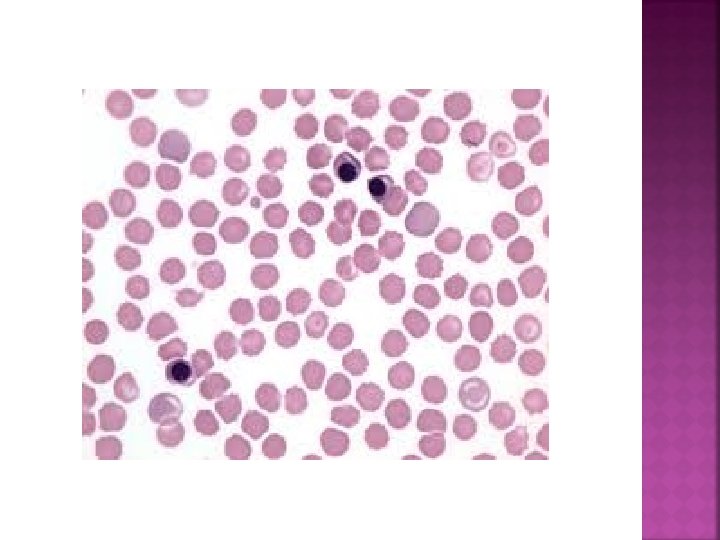

k Goudarzipour Pediatric congenital hematologic disorders research center

















































- Slides: 49


k. Goudarzipour Pediatric congenital hematologic disorders research center Shahid beheshti university of medical science. Tehran. Iran

The neonate is a 2 -day-old with chief complaint of generalize edema. His mother has had 2 abortions. Blood group of mother and her child: O positive. Negative Hx of transfusion in pregnancy, but his mother hasn’t had suitable care in pregnancy.

WBC; 13, 000. p: 70, L: 26, Eo: 4 RBC: 3 Hb: 9 HCT: 27 MCV: 105 MCH: 32 MCHC: 34 PLT: 380, 000 RDW: 14 MPV: 10

What is your DDX?





What additional labs Do you recommend ?




Other lab data in this patient: Retic: 18% LDH: 2300 Bil: 14, Indirect: 12 Coombs test: Negative What additional data do we need?

G 6 PD: NL Pyruvate kinase: decrease

Star cell: pyruvate kinase deficiency

Trisomy 13


mucopolysacaridosis

The patient is a 2. 5 -month-old with chief complaint of pallor. Lab data is shown as below: WBC: 5600, P: 30, L: 70 RBC: 2. 4 Hb: 6. 9 MCV: 84 MCH: 29 MCHC: 31 PLT: 170, 000 RDW: 17 MPV: 9

What additional labs do you recommend and what are DDX?

Retic: 0. 3% PBS: Anisocytosis Hb A: 42. 3% F: 54% A 2: 3. 7%

BM aspiration: Ring sideroblast with moderate decrease in erythroid series ADA: Increased Goudarzipour formula for Hb F: 70 -3(Age based on week-2): 46 His father has minor thalassemia with only increased A 2

Hand abnormality (three phalanges thumb)

Diamond blakfan Anemia + minor thalassemia


The patient is a 3 -month-old term boy with cc of pallor. WBC: 7300 RBC: 2. 4 Hb: 6. 6 HCT: 21 MCV: 53 MCH: 23 MCHC: 24. 5 PLT: 175, 000 RDW: 19

Retic: 12%, corrected Retic: 7% Electrophoresis & HPLC : Normal Supravital staining: Golf ball negative.

Microcytic RBCs Polychromasia Bizarrely shaped cells with fragmentation, poikilocytes, pyknocytes, and microspherocytes

Parents’ CBC: microcytosis in his father with normal electrophoresis

Increased osmotic fragility Decreased acid glycerol lysis time Thermal sensitivity testing shows fragmentation of the RBC at temperatures as low as 45°C. Evaluate the ratio of spectrin/band 3 to determine the spectrin level so that this entity can be differentiated from homozygous hemolytic elliptocytosis.



HEREDITORY PYROPOIKILOCYTOSIS

The patient is a 7 -month-old with cc of pallor and anorexia. CBC is shown below: WBC: 6500, P: 25, L: 75 RBC: 2. 8 Hb: 8. 8 HCT: 27 MCV: 88 MCH: 30 MCHC: 33 PLT: 453000

Retic: %0. 8 PBS: NL ESR: 30 CRP: NL U/A & U/C: NL

e. ADA: NL Hb electrophoresis: NL BMA: moderate decrease in erythroid series.

Under observed after 2 months; Hb was increased to 11.

Transient Erythroblastopenia of Childhood

A male neonate, BW: 2400 g, was born by normal spontaneous delivery to a 28 -year-old , gravida II para I. At presentation there was noticeable pallor and mild generalized edema. A CBC revealed : Hb: 6. 6 g/d. L, hematocrit 22. 1%, WBC: 24000, Neutrophils 54%, l: 46%, plt: 280, 000

Peripheral smear showed marked anisocytosis with RBCs being predominantly macrocytic and presence of polychromasia and nucleated RBCs (28 NRBC/100 WBC), few fragmented and dysmorphic RBCs were also noticed. Retic: 12% Blood Group : Mother and infant: 0+ Coombs test : neg

Kleihauer-Betke stain showed 13. 34% fetal cells, which represented 620 ml of fetal blood loss in the maternal circulation on the basis of 55 kg of mother’s weight.


Kleihauer-Betke test (KBT) Alpha feto protein flowcytometry
